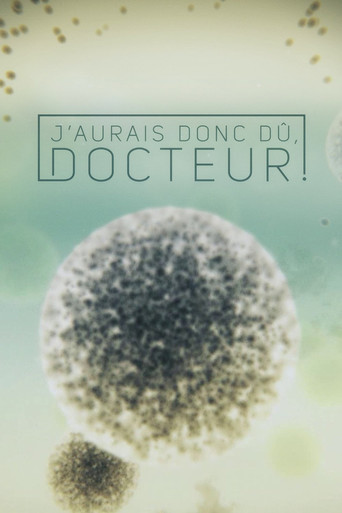
J'aurais donc dû, docteur! poster

Self - Presenter
Michael Mosley
Self - Presenter


In this "entertaining medical series" (The Sunday Times, U.K.), Dr. Michael Mosley shows how drugs have revolutionized medicine and changed the course of human history. Unfolding over a period of 200 years, it's an extraordinary tale of daring, self-experimentation, revelation, genius, and outright luck.
Loading reviews...
More series you might want to watch next.